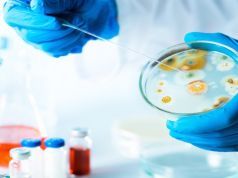
Scientists Determine We Have Auras… of Germs

The Truth about Vitamin B12
In the pursuit of health, products that tout B vitamins as a way of giving us an energy boost may seem appealing. After all,...
Scientists Determine We Have Auras… of Germs
And now for the latest in gross news: New research suggests that we’re surrounded by a cloud of invisible microbes and fart bacteria. As...
Surfing and Climbing Possible 2020 Olympic Events
Tokyo’s Olympic organizing committee has revealed the five sports shortlisted and awaiting approval to be included in the 2020 Olympics. The organizing committee, the...
Suffering from Ulcerative Colitis? Try These Natural Remedies for Relief
Ulcerative colitis can be a painful and difficult disease to manage. There are treatments available, but there is no cure. Fortunately, there are some...
Are Natural Rubber Products the Best Option for Babies?
There are so many cute products available for babies and toddlers, it can be hard to choose. Any number of appealing colors, textures and...
A Third of Our Kids Eat This Every Day
More than a third of America’s children and adolescents have probably consumed fast food today. That’s according to a new report released by the...
Will Google Provide the Key to the Next Discovery in Genomics Research?
Google's expansion into the medical technological field just keeps on growing. In this latest move, Google has announced that it is participating in a...
5 Ways to Get the Most Health Benefits from Your Coffee Drinking Habit
You may have seen reports touting the health benefits of coffee, and rejoiced. It’s awesome to discover scientific evidence that justifies your daily habit. However,...
10 Toxic Things to Get Out of Your Home Now
In the pursuit of a healthier lifestyle, it’s not just food and personal care products that must be carefully vetted. Household and work environments...
Eat This with That: Getting the Most from Your Food
All natural foods contain nutrients that are vital to our health. But did you know that how you combine your foods could also influence...